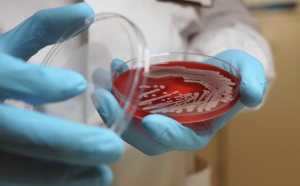

Let’s be realistic–acne is frustrating. Whether it’s a sudden breakout right before your big event or a long-term struggle with pimples constantly popping onto your skin, dealing with acne can be challenging. But understanding why acne happens can help you treat it more effectively, so let’s break it down.
What causes acne?
Acne develops when your pores become clogged with oil (sebum) and dead skin cells, creating an ideal environment for the bacteria to live in. But what actually triggers this process? Here are the key factors that you should be aware of:
1. Hormones: Hormones play the most significant role, especially androgens, which increase during puberty and stimulate the sebaceous glands to produce more oil. This is why a lot of teenagers often experience breakouts. Hormonal changes related to menstruation, pregnancy, and stress can also trigger acne.
2. Excess oil production: Excess oil production also makes some individuals more prone to acne, as it increases the chance of clogged pores. Your sebaceous glands in your skin naturally produce oil to keep your skin hydrated, but too much can clog pores and cause breakouts. So we need to exfoliate our skin to make room for new cell growth and allow the sebum to get where it needs to be!
3. Bacteria: A small amount of bacteria naturally lives on the skin, but an overgrowth of certain types, such as P. acnes, can lead to acne issues. Bacteria can enter through cuts, scrapes, or contact with contaminated surfaces. These bacteria multiply inside these clogged pores, leading to inflammation and breakouts. They also colonize clogged hair follicles on the skin, where it feeds on sebum and produces fatty acids, leading to the formation of acne.
Types of Acne
Not all acne is the same, and recognizing the different types can help in choosing the right treatment! Here are the three types of acne:
1. Non-Inflammatory Acne:
a. Blackheads: These appear as small, dark spots on the skin’s surface. The dark color results from oxidized oil and dead skin cells trapped in the pore, not dirt. They are usually seen on the nose, chin, or forehead.
b. Whiteheads: Whiteheads are similar to blackheads but small, flesh-colored or white bumps that remain beneath the skin’s surface. They occur when pores are clogged with oil and dead skin cells.
2. Inflammatory Acne
a. Papules: These are small, red, raised bumps that appear on the skin, often sensitive or sore when pressed. They don’t have a center of fluid, but they are swollen and can be painful, typically showing up on the face, chest, or the back.
b. Pustules (Pimples): Pustules are red, inflamed bumps with a white or yellow fluid-filled center. They appear as small pimples with a visible “head” and may be uncomfortable or sore to touch. They often occur on the face, back, or shoulders.
c. Nodules: Nodules are large, hard, painful bumps that form deep beneath the skin. They are not easily popped and remain beneath the surface, causing much discomfort. These can leave deep scars if not treated properly!
d. Cysts: Cysts are large, fluid-filled lumps under the skin that appear as painful, swollen, and red lesions. They are filled with a thick fluid and can be very inflamed. Cysts can lead to scarring and often need medical treatment.
3. Hormonal Acne: This type of acne often appears as deep, painful pimples along the jawline, chin, and neck, especially for adults. Hormonal acne tends to come up during menstruation, periods of stress, or other hormonal changes, leading to breakouts in these specific areas.
4. Fungal Acne: Fungal acne looks like small, itchy red bumps. They appear most commonly on the forehead, chest, or the back and are often mistaken for regular acne. These bumps can be treated with antifungal treatments, such as topical ketoconazole, over-the-counter antifungal creams like clotrimazole, or oral antifungals prescribed by a doctor.
How to Treat Acne Effectively
There isn’t a one-size-fits-all solution for acne, but various treatments can help manage it based on its severity.
1. Tropical treatments: Tropical treatments are effective for mild to moderate acne. Salicylic acid helps exfoliate the skin and keeps pores clear, while benzoyl peroxide kills acne-causing bacteria and reduces inflammation. Retinoids, derived from vitamin A, promote cell turnover to prevent clogged pores and improve skin texture over time.
2. Oral medications: These may be necessary for more stubborn cases. Antibiotics work by reducing bacteria and inflammation, while hormonal treatments, such as birth control, help regulate oil production. For severe acne, isotretinoin (also commonly known as Accutane) is a strong option that shrinks sebaceous glands, ultimately reducing breakouts. However, due to its potency, isotretinoin can cause side effects such as dry skin, sensitivity to sunlight, nosebleeds, and, in rare cases, mood changes or liver issues, so it should only be used under medical supervision with regular check-ups!
3. Skincare and lifestyle habits: These helpful habits also play a crucial role in acne management. Washing your face gently prevents excessive oil removal, which can trigger even more oil production. Using non-comedogenic (products designed to keep pores clear) skincare and makeup products ensures that pores don’t become clogged. Some studies also suggest that reducing dairy and high sugar foods may also improve acne and managing stress can prevent hormonal breakouts.
Acne is a common skin condition, but with the right treatments and skincare routine, it can be managed effectively. The important key here is patience and consistency!

Comments are closed.